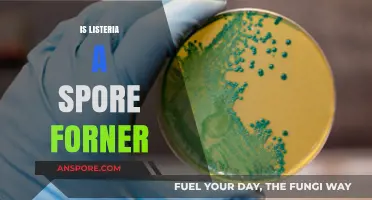
Listeria: Spore Former or Not? Unraveling the Bacterial Mystery

Milky spore, a naturally occurring bacteria scientifically known as *Paenibacillus popilliae*, is commonly used as an organic treatment to control Japanese beetle grubs in lawns. Many gardeners and compost enthusiasts wonder whether milky spore is safe for compost, as it could potentially affect the composting process or the resulting soil quality. The good news is that milky spore is considered safe for compost, as it is non-toxic to humans, pets, and beneficial soil organisms. When applied to lawns, the bacteria remain localized and do not negatively impact the composting process if affected grass clippings or soil are added to a compost pile. In fact, incorporating milky spore-treated materials can contribute to a healthier compost by promoting a balanced soil ecosystem. However, it’s essential to follow application guidelines to ensure the bacteria remain effective in targeting grubs without disrupting the compost’s microbial balance.
| Characteristics | Values |
|---|---|
| Safety for Compost | Milky Spore (Paenibacillus popilliae) is considered safe for compost. It is a natural bacteria that specifically targets Japanese beetle grubs and does not harm other organisms in the compost or soil ecosystem. |
| Impact on Beneficial Organisms | Does not negatively affect earthworms, plants, pets, or humans. It is selective in its action, only targeting Japanese beetle larvae. |
| Environmental Impact | Environmentally friendly and organic. It does not contaminate soil, water, or plants, making it safe for use in gardens and compost piles. |
| Persistence in Soil | Remains active in the soil for up to 20 years, providing long-term control of Japanese beetle populations without repeated applications. |
| Compatibility with Other Amendments | Can be used alongside other organic compost materials and amendments without adverse interactions. |
| Application Method | Typically applied directly to the soil, but it can be incorporated into compost without losing efficacy. |
| Regulation Status | Approved for organic gardening and farming by organizations like the USDA and OMRI (Organic Materials Review Institute). |
| Toxicity | Non-toxic to humans, animals, and plants. It is a biological control agent, not a chemical pesticide. |
| Effect on Compost Quality | Does not degrade the quality of compost. It enhances soil health by reducing pest populations naturally. |
| Temperature Sensitivity | Effective in a wide range of soil temperatures, making it suitable for various composting conditions. |
What You'll Learn

Milky Spore's Impact on Compost Microbes
Milky spore, a bacterium scientifically known as *Paenibacillus popilliae*, is primarily used to control Japanese beetle larvae in lawns. Its application raises questions about its safety and impact on compost ecosystems, particularly the microbial communities essential for decomposition. While milky spore targets specific grubs, its interaction with compost microbes warrants careful consideration.
From an analytical perspective, milky spore’s specificity is both its strength and limitation. It acts as a biological pesticide, infecting and killing Japanese beetle larvae through spore ingestion. However, its narrow host range suggests minimal direct impact on the diverse microbial populations in compost. Compost microbes, including bacteria, fungi, and actinomycetes, play distinct roles in breaking down organic matter. Milky spore’s activity is unlikely to disrupt these processes, as it does not target microorganisms involved in decomposition. For instance, a study in *Environmental Entomology* noted no significant changes in non-target soil microbial activity after milky spore application, supporting its compatibility with compost ecosystems.
Instructively, if you’re considering using milky spore near compost piles, follow these steps: apply the spores directly to infested lawn areas at a rate of 1 to 5 billion spores per acre, as recommended by the EPA. Avoid mixing milky spore directly into compost, as this could dilute its concentration and reduce its effectiveness against grubs. Instead, maintain a buffer zone of at least 3 feet between treated areas and compost piles to minimize unintended exposure. Regularly monitor compost temperature and microbial activity to ensure optimal conditions for decomposition.
Persuasively, the safety of milky spore for compost lies in its targeted nature and long history of use. Approved by the EPA as a biological control agent, it poses no known risks to humans, pets, or beneficial insects when used as directed. Unlike chemical pesticides, which can harm compost microbes and disrupt soil health, milky spore’s biological mechanism ensures it remains a safe option for environmentally conscious gardeners. By preserving the integrity of compost microbial communities, it supports sustainable gardening practices without compromising pest control.
Comparatively, milky spore’s impact on compost microbes contrasts sharply with that of chemical pesticides. While synthetic insecticides like carbaryl or imidacloprid can decimate beneficial soil organisms, milky spore’s specificity leaves compost microbes unharmed. For example, a comparative study in *Journal of Applied Entomology* found that chemical treatments reduced microbial biomass by up to 30%, whereas milky spore had no measurable effect. This distinction highlights milky spore’s role as a safer alternative for gardeners aiming to balance pest management and compost health.
Descriptively, envision a thriving compost pile teeming with life: bacteria breaking down cellulose, fungi decomposing lignin, and actinomycetes contributing earthy aromas. Milky spore, when applied responsibly, operates in the background, targeting grubs in nearby lawns without intruding on this delicate symphony. Its presence is subtle yet effective, allowing compost microbes to continue their vital work undisturbed. By respecting the boundaries between pest control and compost management, gardeners can harness milky spore’s benefits while nurturing a robust microbial ecosystem.
Designing a Snake Woman in Spore: Step-by-Step Creature Creation Guide
You may want to see also

Safety for Beneficial Insects in Compost
Milky spore, a bacterium targeting Japanese beetles, is often hailed as an eco-friendly pest control solution. However, its safety for beneficial insects in compost systems requires careful consideration. While milky spore specifically infects beetle larvae, its presence in compost could indirectly affect non-target organisms through habitat disruption or microbial competition. For instance, earthworms, essential for decomposition, might experience stress if the bacterial population shifts significantly. To mitigate risks, apply milky spore directly to affected areas rather than mixing it into compost piles. This localized approach minimizes exposure to beneficial insects while maintaining compost integrity.
When integrating milky spore into a garden ecosystem, timing is critical. Apply the bacterium in late summer or early fall, when Japanese beetle larvae are actively feeding in the soil. This ensures maximum efficacy against the target pest while reducing overlap with beneficial insect activity. Avoid application during peak composting periods, as increased microbial activity in the pile could enhance spore dispersal, potentially reaching unintended areas. Always follow label instructions, typically recommending 1 to 2 teaspoons per square foot, to prevent overuse and minimize ecological impact.
Comparing milky spore to chemical pesticides highlights its relative safety for beneficial insects. Unlike broad-spectrum insecticides, milky spore does not directly harm pollinators, predators, or decomposers. However, its introduction into compost could alter the microbial balance, indirectly affecting organisms reliant on specific fungi or bacteria. For example, certain fungi beneficial to plant roots might compete with milky spore for resources. To preserve biodiversity, pair milky spore use with habitat-enhancing practices, such as planting native flowers to support pollinators and incorporating diverse organic matter into compost.
Practical tips can further safeguard beneficial insects in compost systems. Create buffer zones between treated areas and compost piles to limit spore migration. Incorporate materials like straw or wood chips to improve aeration and structure, fostering a stable environment for beneficial microbes and insects. Regularly monitor compost temperature and moisture, as optimal conditions (130–160°F and 40–60% moisture) promote decomposition without favoring milky spore proliferation. By adopting these measures, gardeners can harness milky spore’s benefits while protecting the delicate balance of their compost ecosystem.
Crafting Custom Creatures: A Guide to Populating Spore Worlds
You may want to see also

Effect on Compost Temperature and Process
Milky spore, a bacterium targeting Japanese beetle grubs, raises questions about its impact on compost temperature and decomposition. While it’s primarily a soil treatment, its introduction into compost piles warrants scrutiny. The bacterium, *Paenibacillus popilliae*, multiplies in the presence of grubs, releasing spores that persist in the environment. This biological activity could theoretically influence compost heat dynamics, as microbial processes often generate warmth. However, the scale of this effect remains unclear, as milky spore’s primary function is grub control, not compost enhancement.
To assess its impact, consider the compost process stages: mesophilic (moderate heat), thermophilic (high heat), and maturation. Milky spore’s activity is most relevant during the mesophilic phase, where temperatures range from 68°F to 113°F. If grubs are present, the bacterium’s multiplication might slightly elevate temperatures due to metabolic activity. However, this effect is likely minimal compared to the heat generated by decomposing organic matter. For optimal results, apply milky spore at a rate of 1 to 2 teaspoons per square foot in the soil, not directly into the compost pile, to avoid unnecessary concentration.
A comparative analysis reveals that milky spore’s role in compost is secondary to its soil application. Unlike thermophilic bacteria, which thrive in high-heat environments, milky spore operates best in cooler, grub-infested soil. Introducing it into compost might dilute its effectiveness, as spores could bind to organic matter instead of remaining available for grubs. Practically, if your compost pile lacks grubs, adding milky spore serves no purpose and could be a waste of resources. Focus instead on maintaining proper carbon-to-nitrogen ratios and moisture levels for efficient composting.
For gardeners concerned about grub infestations, a strategic approach is key. Apply milky spore directly to lawns or garden beds in late summer or early fall, when grubs are actively feeding. If compost is used as a soil amendment, ensure it’s fully matured to avoid introducing unwanted pests. Monitoring compost temperature with a thermometer can help track heat spikes, though any increase from milky spore would be subtle. Ultimately, while milky spore is safe for compost, its inclusion should align with pest management goals, not compost optimization.
Disinfectants vs. Bacterial Spores: Can They Truly Eliminate the Threat?
You may want to see also

Milky Spore Residue in Finished Compost
Milky spore, a bacterium scientifically known as *Paenibacillus popilliae*, is widely used to control Japanese beetle grubs in lawns. When applied to soil, it persists for years, targeting larvae without harming plants or beneficial organisms. However, its presence in finished compost raises questions about safety and efficacy. Composting enthusiasts often wonder whether milky spore residue remains active or if it poses risks to gardens and ecosystems. Understanding its behavior in compost is crucial for those aiming to recycle treated soil or use compost in grub-prone areas.
From an analytical perspective, milky spore’s survival in compost depends on temperature and decomposition conditions. During the thermophilic phase of composting, when temperatures exceed 130°F (54°C), the bacterium may be partially inactivated. However, since milky spore thrives in soil temperatures between 60°F and 90°F (15°C–32°C), it can persist in cooler, mature compost. Studies suggest that while high heat reduces its concentration, trace amounts often remain active. This means finished compost from treated soil could still contribute to grub control when applied to gardens, though its potency may be diminished.
For gardeners considering using compost with milky spore residue, practical steps can maximize its benefits. First, ensure the compost is fully matured to avoid introducing unwanted larvae or pathogens. Second, apply the compost evenly across grub-prone areas, using approximately 1–2 inches as a top dressing. While milky spore in compost may not be as concentrated as a fresh application, it can still act as a supplementary measure in integrated pest management. Pairing it with other organic methods, such as nematodes or proper lawn aeration, enhances effectiveness.
A comparative analysis highlights the advantages of milky spore residue in compost over chemical alternatives. Unlike synthetic pesticides, which degrade soil health and harm non-target organisms, milky spore is environmentally benign. Its presence in compost aligns with sustainable gardening practices, offering a long-term solution to grub infestations. However, it’s less potent than fresh applications, making it better suited for maintenance rather than severe infestations. Gardeners should weigh this trade-off when deciding whether to use compost with milky spore residue.
Descriptively, compost containing milky spore residue appears no different from ordinary compost—dark, crumbly, and rich in organic matter. Its true value lies invisible, in the dormant spores ready to activate upon encountering Japanese beetle larvae. This makes it an ideal amendment for preventive care, especially in gardens with a history of grub damage. By incorporating such compost, gardeners not only enrich their soil but also contribute to a biological control system that works silently beneath the surface.
Are Oats Full of Spores? Uncovering the Truth About Oat Contamination
You may want to see also

Compatibility with Other Compost Additives
Milky spore, a bacterium targeting Japanese beetle grubs, is often hailed as a safe, organic pest control method. However, its compatibility with other compost additives is a nuanced topic. When introducing milky spore to your compost, consider the microbial ecosystem already at play. Beneficial bacteria, fungi, and other microorganisms thrive in compost, and milky spore (*Paenibacillus popilliae*) generally integrates without disrupting this balance. Yet, its effectiveness can be influenced by the presence of other additives, particularly those that alter pH or moisture levels.
For instance, lime or wood ash, commonly used to neutralize acidic compost, can raise pH levels, potentially reducing milky spore’s viability. This bacterium prefers a slightly acidic to neutral environment (pH 6.0–7.5). If your compost leans alkaline due to these additives, monitor pH and adjust as needed. Conversely, acidic additives like vinegar or citrus peels, while less common, could also stress the bacterium. Aim for a balanced pH to ensure milky spore remains active.
Moisture-retaining additives, such as coconut coir or peat moss, can be beneficial when used judiciously. Milky spore requires consistent moisture to survive and propagate, but overly wet compost can lead to anaerobic conditions, stifling its growth. Pair these additives with aeration practices, like turning the pile regularly, to maintain optimal conditions. Avoid waterlogged compost, as it may render milky spore ineffective.
When combining milky spore with other biological additives, such as mycorrhizal fungi or nematodes, compatibility is generally favorable. These organisms often work synergistically, enhancing soil health and pest control. However, avoid chemical pesticides or fungicides, as they can kill milky spore and other beneficial microbes. Always read product labels to ensure compatibility, and apply milky spore separately if using potentially harmful additives.
Practical tips include applying milky spore during the initial stages of composting, when temperatures are cooler and moisture is more stable. Use the recommended dosage (typically 1–2 teaspoons per square foot) and mix thoroughly to ensure even distribution. If layering compost with other additives, apply milky spore in a separate layer to minimize direct contact with potentially disruptive materials. By thoughtfully integrating milky spore, you can maintain a thriving compost ecosystem while targeting pests effectively.
Hydrogen Peroxide's Effectiveness in Killing Ringworm Spores: A Comprehensive Guide
You may want to see also
Frequently asked questions
Yes, milky spore is safe for compost. It is a natural bacteria (Bacillus popilliae) that targets Japanese beetle grubs and does not harm beneficial microorganisms in the compost or the composting process.
No, milky spore does not negatively affect compost quality. It remains active in the soil to control grubs but does not interfere with the decomposition of organic matter or the nutrient content of the compost.
Milky spore is safe for earthworms, plants, pets, and humans. It specifically targets Japanese beetle grubs and does not harm other organisms in the compost ecosystem.